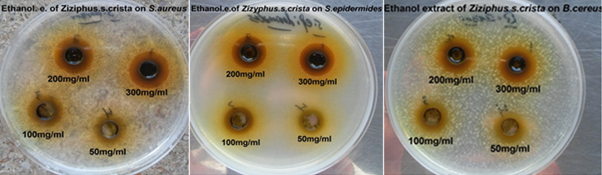

Journal of
eISSN: 2373-437X


Research Article Volume 9 Issue 5
Department of Food science & Technology, Faculty of Agriculture, Sana’a University, Yemen
Correspondence: Rasheed Al-Husami, Department of Food science & Technology, Faculty of Agriculture, Sana’a University, Yemen, Tel 00967-773315305
Received: October 15, 2021 | Published: October 28, 2021
Citation: Al-zaemey A, Abdullah AB, Al-Husami R. A study of antimicrobial and antioxidant activity to ethanolic extract of sider (Ziziphus spina-christi) leafs against some Pathogenic microorganisms. J Microbiol Exp. 2021;9(5):172-176. DOI: 10.15406/jmen.2021.09.00339
The antimicrobial activity of ethanolic extracts of Ziziphus spina- christi leafs were examined by using agar well diffusion method against five bacteria (Staphylococcus aureus, Pseudomonas aeruginosa, Bacillus cereus, Escherichia coli and Staphylococcus epidermides) in addition to Candida albicans. Results of this present study indicated that the ethanol extract of Ziziphus spina- christi leafs was effective against tested gram positive and negative bacteria whereas the C. albicans was showed resistance to this extract. Results showed that the gram positive bacteria more sensitivity to ethanolic extract of Ziziphus spina- christi leafs at all concentration used (from 5% to 30%) than gram negative bacteria. The highest inhibition zone was by a high concentration of Ziziphus spina-christi ethanolic extract 30% against S. aureus with inhibition zone equal (19mm) while, the lower inhibition zone given by second concentration 20% against P. aeruginosa with inhibition zone equal to (9mm). The results of the 1,1-diphenyl-2-picrylhydrazyl (DPPH) scavenging activity of ethanolic extract possess high antioxidant activity at different concentrations with IC50 value equal to 176µg ml compared to the IC50 value of control sample (L-Ascorbic acid) equal to 145.88µg/ml.
Keywords: antimicrobial activity, antioxidant activity, Ziziphus spina-christi, ethanolic extract, pathogenic microorganisms
Medicinal plant is defined as any plant which in one or more of its parts contains substance that can be used for therapeutic purpose or as precursors for the synthesis of useful drugs.1 The medicinal plants have been used for traditional health remedies and considered the most popular for 80% of world population in Asia, Latin America and Africa and is reported to have minimal side effects.2 In recent years, there is most interest in drugs derived from plants. This interest primarily stems from the belief that green medicine is safe and dependable, compared with costly commercial synthetic drugs that have adverse effects.3,4
The family of Rhamnaceae included many genuses that have medicinal importance. One of these genuses is Ziziphus that comprises about 100 species of deciduous or evergreen trees and shrubs. distributed in the tropical and subtropical regions of the world. All parts of the plant Ziziphus has medicinal importance and used by the local Arab people to help maintain a healthy life style.5 Various species of Ziziphus are used frequently in traditional medicine in the middle-east, Africa and some Asian countries for acquiring good health and treating of many ailments; including headache, fever common cold, asthma, pulmonary ailment, malaria, wounds, burns, stomach discomfort and urinary infections.6
Ziziphus spina-hristi has been used in folk medicine as a depurative, demulcent, anodyne, stomach-ache, toothaches, emollient, astringents, antibacterial, antifungal and as a mouth wash.7,8 Plant products are rich sources with different biological compounds, mainly phenolics, various flavonoids, saponins, tannins, betulinic, ceanothic acids, erols, and triterpenes. These phytochemicals have been found to possess different biological properties like antioxidant and antimicrobial effect.9,10 The leafs are used to sores remedy, and the roots are used to cure and prevent skin diseases.5 The seeds are sedative and are taken sometimes with buttermilk to halt nausea, vomiting and abdominal pains associated with pregnancy.11 Ziziphus spina-Christi (L.) has been reported to have activity against bacterial and fungal pathogens that are normally quite resistant to modern medications.12
The main objective of this study to investigate potential uses of Ziziphus spina- christi as antimicrobial and antioxidant against some foodborne pathogens and using ethanolic extract of Ziziphus spina- christi as alternative food preservative agent.
Preparation of sample
Sample collection
The useful plant leafs were collected from Yemen - Taize government - Bani Alhusam and identified according to guideline of the.13,14 The collected plant material was dried in an open air protected from direct exposure to sun light. All dried plant sample was finely ground by using an electrical grinder to a fine powder and made ready for extraction.
Preparation of extract
The sample of Ziziphus spina- christi leafs was extracted by using 1:10 in ethanol 80% at room temperature for 48 hours with occasional shaking. Then filtered by using filter paper (Whatman No 1.5, whatman Ltd., England). The extract was evaporated to dryness in oven at 45ºC to yield dry crude extract. The obtained crude extract was filled to amber tight closed bottle glass in refrigerator until uses.
Antimicrobial assay
Microorganisms used
The microbial strains were get from faculty of science, Sana’a university, republic of Yemen in April-2018. These microorganisms include:
Pseudomonas aeruginosa MTCC2453 Mar.2001, Escherichia coli MTCC739 Mar.2001, Staphylococcus aureus (ATCC653-8), Staphylococcus epidermides (local isolate), Bacillus cereus (ATCC6633) and Candida albicans (ATCC2019).
The bacterial strains were maintained on tryptone soya agar (TSA) and the fungal strains were maintained on Sabouraud dextrose agar (SDA).
Antimicrobial and Antibiotic assays
The Antimicrobial and Antibiotic assay was performed by using Agar Well Diffusion Method according to.15,16
Antimicrobial assay
Four different concentrations of each extract of selected plants {300mg/ml (30%), 200mg/ml (20%), 100mg/ml (10%) and 50mg/ml (5%)} were dissolved in 10% {dimethylsulfoxide (DMSO) in Phosphate buffered saline} to be used in antimicrobial assay test. Extract solutions were prepared just before carrying out the test. Antimicrobial activity of the extracts was determined by agar well diffusion method as described by15,16 on Tryptone soya Agar (TSA).
In each of these Plates four wells were cut out by using a standard cork borer (8 mm). About 60μl of each extract was added into different wells (triplicate each concentration). DMSO was used as a negative control. A positive control antibiotic disc was placed in the other plate. All the plates were incubated for 24h at 37°C. After incubation bioactivity was evaluated by measuring the zone of inhibition. All the experiment was performed in triplicates.
Antibiotic assays
The Antibiotic assay was performed by using antibiotic standard disc diffusion. The antibiotic standard disc was get from HiMedia and oxoid company which are Aztreonam (AT30), Ceftazidin (CAZ30), Co-Trimoxazole (COT25), Gentamycin (Gen10), Nystatin (100IU), Norfloxacin (NOR5) and Vancomycin (VA30)
Determination of DPPH radical scavenging activity:
The antioxidant activity of the ethanolic extract, on the basis of the scavenging activity of the stable 1,1-diphenyl-2-picrylhydrazyl (DPPH) free radical, with some modification according to.17 The antioxidant activity of the plant extract was estimated for a typical reaction, 1 ml of 0.2mM DPPH solution in methanol was mixed with 1 ml of (1, 0.5, 0.25 mg/ml ) of plant extract . The reaction mixture was incubated in the dark for 15 min. L-ascorbic acid was used as standard antioxidants and methanol was used as the control. An aliquot of 2 ml of a methanolic solution of DPPH (0.2mM DPPH) was added into the different concentration (1, 0.5, 0.25 mg/ml) of each extract and ascorbic acid as long as control sample (both extract and ascorbic acid were dissolved in methanol). All samples were incubated in the dark at room temperature for 15 min before absorbance values were read at 517 nm (PerkinElmer UV. visible spectrophotometer).The decrease in absorbance was calculated as an IC50 and expressed as µg/ml, which is the concentration of sample required for 50% scavenging of DPPH radicals in the specified time period. The radical scavenging effect was calculated as follows:18
Radical scavenging effect (%) = Ac – As/Ac × 100
Ac = absorbance of control
As = absorbance of test sample.
Where control is the absorbance of the DPPH radical + methanol.
Antimicrobial activity of ethanol extract
The results showed in Table 1 explain the efficacy of the difference in the concentration as well as the type of tested microorganisms on the antimicrobial efficacy of the ethanol extract of the Ziziphus spina-christi which is directly proportional to the increase in concentration, that ranged between 5% and 30% where it was found that the ethanolic extract have antimicrobial activity against all tested microorganisms except C. albicans, which was resistance to this extract. Results also referred that the gram positive bacteria more sensitive than gram negative bacteria where the higher diameter of inhibition zone was 19 mm against S. aureus at the highest concentration 30%. While the lowest value of inhibition zone diameter was 9 millimeters against P. aeruginosa at the second concentration 20%.The results of sensitive and resistant of antibiotics (standards) was high with COT25 (35mm) with gram-negative bacteria E. coli whereas the results showed resistance of P. aeruginosa to antibiotic (COT25 and VA30) respectively (Figure 1).
|
Type microorganism |
Concentration mg/ml(%) |
Name of antibiotic standard |
|||||||||
|
5% |
10% |
20% |
30% |
AT30 |
CAZ30 |
NOR5 |
Gen10 |
COT25 |
VA30 |
Nys100IU |
|
|
Zone of inhibition in mm |
|||||||||||
|
Staphylococcus aureus |
15 |
15.5 |
18.5 |
19 |
0 |
23 |
20 |
22 |
28 |
21 |
NT |
|
Staphylococcus epidermides |
12.5 |
14 |
16 |
17 |
0 |
19 |
20 |
23 |
28 |
22 |
NT |
|
Bacillus cereus |
13 |
14.5 |
16.5 |
17 |
0 |
24 |
30 |
27 |
34 |
30 |
NT |
|
Pseudomonas aeruginosa |
R |
R |
9 |
12 |
24 |
21 |
12.5 |
21 |
0 |
0 |
NT |
|
Escherichia coli |
R |
R |
9.5 |
12 |
29 |
27 |
26.5 |
19.5 |
35 |
12 |
NT |
|
Candida albicans |
R |
R |
R |
R |
0 |
0 |
0 |
0 |
0 |
0 |
13.8 |
Table 1 Ethanolic extract activity of Ziziphus spina – christi against tested microorganism at different concentrations
NT=not test R=resistance
Figure 1 Inhibition zone diameters of Ziziphus spina- christi ethanolic extract against tested microorganisms.
DPPH radical scavenging activity
Results in table 2 revealed that the high antioxidants activity of Ziziphus spina- christi ethanol extract equal 92.32% at higher concentration (1 mg/ml) in comparison with those for sample control (L-ascorbic acid) equal 94.09% and with inhibitory concentration 50% (IC50) value equal 176ug/ml compared to the IC50 value of control sample (L-Ascorbic acid) that equal 145.88. The free radical scavenging efficacy was increasingly with the increased in concentration (Figure 2).
Type of extract |
Radical scavenging effect % |
||||
Concentration |
|||||
250µg/ml |
500µg/ml |
1000µg/ml |
means |
IC50µg/ml |
|
ethanol |
92.326 |
93.484 |
94.0957 |
93.302 |
176 |
L-ascorbic acid |
96.76391 |
96.83067 |
96.88698 |
96.827 |
145.8838 |
L.S.D at(P<0.05)for extracts = 0.0057 |
|||||
Table 2 DPPH scavenging activity to ethanolic extract of Ziziphus spina-christi leafs
Antimicrobial Activity of ethanol extract
In ethanolic extract the highest antimicrobial activity was at 30% and 20% against all tested microorganisms except C. albicans that displayed resistance to all tested concentrations. The lower concentrations (10 and 5%) revealed antimicrobial effect only against gram positive bacteria (S. aureus, S. epidermides and B. cereus) While, gram-negative bacteria (P. aeruginosa and E. coli) resistant to the lower concentrations.
This Findings were in agreement with previous studies conducted by8,19-24 who reported that there was antimicrobial activity against S.aureus. Results conducted by2 that was found the alcohol extract of Ziziphus spina- christi leafs is high antimicrobial effect against bacterium B. cereus. As for the activity ethanol extract of the Ziziphus spina- christi plant against E. coli bacterium the results were confirmed with the previous studies2,8,21,25,26 who mentioned that the ethanol extract of the Ziziphus spina- christi leafs have inhibitory efficacy against E. coli bacterium. Results conducted by24,27 display the antimicrobial activity against P. aeruginosa this results agreed with the present study. On the regarding to effect of ethanol extract against E. coli the results disagree with study of.24 On the other hand the results disagree with results of20,2 which showed a significant effect of the ethanol extract against the C. albicans. Study by2 concluded that the antimicrobial activity of Ziziphus spina-christi leafs extract on microorganisms increase with the increased in concentration. The activity of some extracts may be returned to presence of some effected compounds such as phytokumanins (a type of phenolic compound that has the ability to break down molecular biofilms). This efficacy was related to the high level of not only by the monoterpene hydrocarbons28 but also by the tannins which bind cell walls of ruminal bacteria.22 The high activity of the alcoholic extract is due to the low value of acidity (pH) compared to some other extracts.29 The same studies indicated to that Ziziphus spina-christi leafs contain several organic acids such as malic, citric, tannic, acetic and other acids that lead to a decrease in the acid function (pH) which increases the antimicrobial efficacy of the extract.
Antioxidant activity
The results of this study was appeared high antioxidant activity to ethanolic extract of Ziziphus spina- christi leafs comparing to results of standard (Ascorbic acid). The results was in agreement with the results of previous study by23 about quantification of total phenolic, flavonoids and tannins in ethanol extract of other genus of Ziziphus (Ziziphus lotus and Ziziphus jujube) from many regions in Tunisia and their antimicrobial and antioxidants activity. The antioxidant activity of Ziziphus spina-christi attribute to its high quantity of phytochemical compounds (phenols, flavonoids, cardiac glycosides, polyphenols, saponins and tannins).23,30 The phytochemicals activity was correlated with their chemical structures and degrees of polymerization.31 Sterols like ß-sitosterol, terpenoid, phytosterols, triterpenoids, alkaloids, saponins, flavonoids, glycosides and tannins have been reported to have antioxidant activity.32,33 This antioxidant activity attribute to structure of phytochemicals content where flavonoids contain conjugated ring structures and hydroxyl groups that have the probable to function as antioxidants in vitro or cell free systems by scavenging lipid peroxyradicals, superoxide anion, singlet oxygen and stabilizing free radicals involved in oxidative processes through hydrogenation or complexing with oxidizing species.34,35 Flavonoids can be act by various ways to prevent injury caused by free radicals. Through in vitro experiments, it has been found that flavonoids possess anti-inflammatory, antiviral, antiallergic and anticarcinogenic properties.36 The flavonoids prevent synthesis of prostaglandins that suppress T-cells by forming prominent inhibitors of cycloxygenase and lipoxygenase. The immune cells communicate with chemical signals called cytokines, which are controlled by flavonoids.37 Flavonoids directly act as antioxidant by reducing free radicals to produce a more stable and less reactive radical (oxidize the flavonoids).38-41
The high antioxidant and antimicrobial clear efficiency to ethanolic extract of Ziziphus spina Christi leafs against many of microbial strains that causes different important diseases to human and animal confirming the traditional herbal medicines usages and provide a scientific basis for traditional medicine uses of Ziziphus spina Christi leafs ethanolic extract in primary health care.
None.
Authors declare that there is no conflict of interest.

©2021 Al-zaemey, et al. This is an open access article distributed under the terms of the, which permits unrestricted use, distribution, and build upon your work non-commercially.